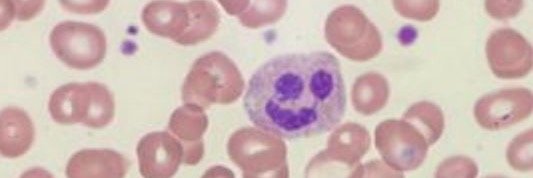
Dr. José A. Queizán Hernández banner

Dr. José A. Queizán Hernández retweetledi

🩸 Segovia se suma a la I Ruta de Maratones de Donación de Sangre en Castilla y León.
📅 25 de marzo
📍 Acueducto
🕘 10:00–13:00 | 15:45–21:15
Con @donasangreCYL para reforzar reservas antes de #SemanaSanta
#Sacyl #DonaciónDeSangre #Segovia

Español